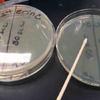

| ||||
Science Image Library: Microbiology Photos
Science Image Library
Microbiology
1.Normal flora bacterial colonies from an arm plate.
2. Bacillus subtilis colonies.
3. Micrococcus luteus bacterial colonies on TSY streak plate.
5. Enterococcus bacterial colonies growing in slant tube.
1.Blood agar with beta-hemolysis on left and alpha-hemolysis on right.
2. Test tube of liquid media showing flocculated bacterial growth.
3. Mannitol Salt Agar with plated nasal sample, normal flora on left and mannitol fermenter on right.
4. Slant tubes growing various bacteria.
5. Sterile TSY agar in bottle.
1. Loaded dishwasher with dirty dishes.
2. Using cotton swab to obtain a sample from interior of dishwasher.
3. Girl obtaining bacterial sample from dishwasher.
4 & 5. TSY plate with bacterial sample from dirty dishwasher on top half, and no bacterial growth from clean dishwasher sample on bottom half.
1. Animal cells: Human cheek epithelial cells stained with methylene blue and magnified 400xTM.
2. Elodea plant cells showing cell walls and chloroplasts (green).
3 & 4. Plant cells: Onion epidermal cells magnified 100xTM & 400xTM.
5. Stained mixed protozoans.
1. Lab set-up for chemical control of bacteria comparing effectiveness of Lysol to bleach.
2. Effectiveness of UV radiation in controlling bacteria. UV exposed plate on left, with only one colony, plate protected from UV rays on right covered with bacteria.
3 & 4. Zones of inhibition from antibiotic disks on on bacteria-covered TSY plates.
1 & 2. Mouthwash experiment comparing Listerine and Crest mouthwash.
3. Test tubes of Listerine, Crest mouthwash and control with water.
4. Oral sample being plated on TSY agar.
1.Autoclave; 2. Microincinerator; 3. Disposable pipette; 4. Compound light microscope; 5. Inoculation wand on Petri dish containing TSY agar.
1.Safranin counterstain of Gram stain.
2. Gram-stained Staphylococcus 1000xTM.
3. Gram-stained slide, controls on ends unknown in center.
4. Acid-fast stain mixed (+/-) 1000xTM.
5. Endospore stain (+) 1000xTM.
Microbiology Equipment
(Click on image to enlarge. See more > Microbiology Equipment)
Mouthwash Experiment (Click on image to enlarge.)
Microbial Control (Click on image to enlarge.)
Eukaryotic Cells
(Click on image to enlarge. See more > Eukaryotic Cells)
Dishwasher Experiment (Click on image to enlarge.)
Bacterial Staining
(Click on image to enlarge. See more > Bacterial Stains)
Bacterial Growth Media
(Click on image to enlarge. See more > Bacterial Growth Media))
Bacterial Colonies & Streak Plates
(Click on image to enlarge. See more > Colonies & Streak Plates)
API-20E Strips For Identifying Gram- Bacteria
SPO VIRTUAL CLASSROOMS
 | ||||||
SCIENCE VIDEOS
VIDEO: How to Do a Gram Stain
VIDEO: MacConkey's Agar (MAC) Specialized
Bacterial Growth Medium
The Microbiology Image Library is the largest photo collection on the SPO site. To help you more easily find what you're looking for, select the "See more" link of the sub-topic below that corresponds to your interests or use the search boxes.
The SPO Science Image Library is a continuously growing collection of copyright-free science photographs. If you use one of our free, low-res images, we just ask that you give us credit and provide a link to the SPO website (scienceprofonline.com). Click on photo to enlarge. To save a photo to your computer, right click on it and select "Save".
More Useful Microbiology Resources
- Microbe Wiki, Kenyon College
- I Love Bacteria website
- Microbe World, American Society of Microbiology
- Microbiology Flashcards from Quizlet
- For additional resources see our Microbiology Education Links page.
You have free access to a large collection of materials used in a college-level introductory microbiology course. The Virtual Microbiology Classroom provides a wide range of free educational resources including PowerPoint Lectures, Study Guides, Review Questions and Practice Test Questions.
Didn't find what you need?
Search SPO for a Photo
Page last updated 1/2016
For those in need of high-resolution images, we will soon be offering hi-res files of many photos in the Science Image Library. Follow us on Facebook to get updates on new SPO features and products. If you need a high resolution photo now, please contact us.
 | ||||||
SPO is a FREE science education website. Donations are key in helping us provide this resource with fewer ads.
Please help!
(This donation link uses PayPal on a secure connection.)
 | ||||
The VMC offers homework assignments based on Radiolab podcasts.
RADIOLAB PODCASTS:
HOMEWORK ASSIGNMENTS:
Need Help Pronouncing the Crazy Scientific Names of Microbes?
Visit the
You have FREE access to a large collection of materials used in a college-level introductory biology course. The Virtual Biology Classroom provides a wide range of free educational resources including PowerPoint Lectures, Study Guides, Review Questions & Practice Test Questions.